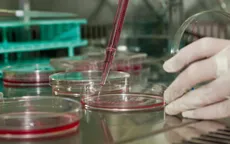
EU đề xuất công khai các tài liệu khoa học từ năm 2020

tài liệu khoa học

Tiếp cận hàng triệu tài liệu khoa học qua điểm truy cập mở quốc gia
VTV.vn - Thông qua điểm truy cập mở thông tin về khoa học công nghệ, bạn đọc có thể tiếp cận, tìm kiếm hàng triệu tài liệu nghiên cứu khoa học tại đây.
EU đề xuất công khai các tài liệu khoa học từ năm 2020
VTV.vn- Theo đề xuất của Hội đồng cạnh tranh EU, các kết quả nghiên cứu khoa học được tài trợ bởi ngân sách công sẽ được công bố công khai và có thể tiếp cận miễn phí từ năm 2020.

